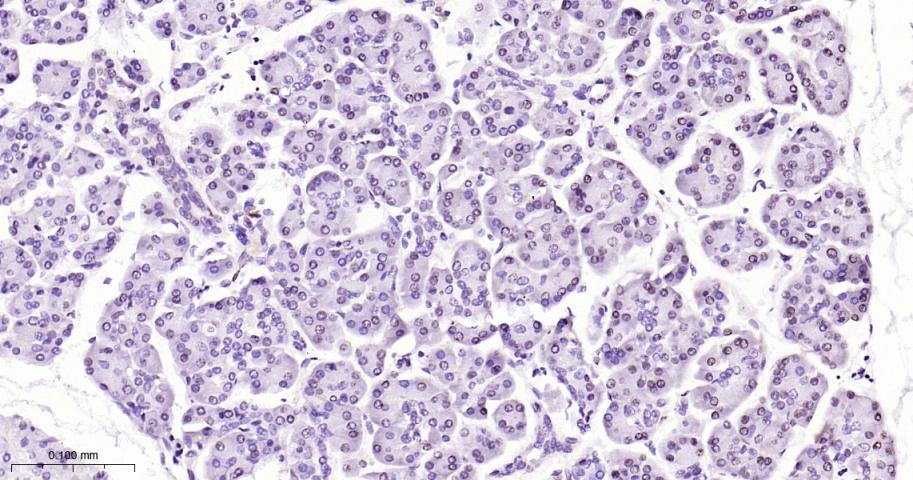
phospho-STAT3 (Tyr705) Mouse m

相关产品推荐更多 >

CD44v7 Rabbit pAb, PerCP-Cy5.5 conjugated(bs-16206R-PerCP-Cy5.5)-100ul
¥2980
HOPX/LAGY Rabbit pAb, RBITC conjugated(bs-9462R-RBITC)-100ul
¥2980
Nanog Rabbit pAb, PerCP conjugated(bs-0829R-PerCP)-100ul
¥2980
FIGNL2 Rabbit pAb(bs-16088R)-50ul/100ul/200ul
¥1180
HP1 gamma Mouse mAb, Biotin conjugated(bsm-33375M-Bio)-100ul
¥2980
万千商家帮你免费找货
0 人在求购买到急需产品
- 详细信息
- 文献和实验
- 技术资料
- 应用范围:
产品信息以Bioss网站为准
- 规格:
50ul/100ul/200ul/200ug
| 规格: | 50ul | 产品价格: | ¥1180.0 |
|---|---|---|---|
| 规格: | 100ul | 产品价格: | ¥1980.0 |
| 规格: | 200ul | 产品价格: | ¥2800.0 |
| 规格: | 200ug | 产品价格: | ¥5600.0 |
| 产品编号 | bsm-33301M |
| 英文名称 | phospho-STAT3 (Tyr705) Mouse mAb |
| 中文名称 | 磷酸化信号转导和转录激活因子3单克隆抗体 |
| 英文别名 | STAT3(phospho Y705); p-STAT3(phospho Y705); phospho-Stat3(pTyr705); STAT3(phospho-Tyr705); p-STAT3(Tyr705); phosphorylated Stat3(pTyr705); p-Stat3; Acute Phase Response Factor; APRF; DNA binding protein APRF; FLJ20882; MGC16063; Signal Transductor and Activator of Transcription 3; STAT 3; STAT3_HUMAN. |
| 产品应用 | IHC-P=1:100-500, IHC-F=1:100-500, IF=1:100-500 Not yet tested in other applications. |
| 交叉反应 | Human, Rat |
| 抗体来源 | Mouse |
| 免疫原 | KLH conjugated Synthesised phosphopeptide derived from human STAT3 around the phosphorylation site of Tyr705 |
| 亚型 | IgG |
| 性状 | Liquid |
| 纯化方法 | affinity purified by Protein G |
| 克隆类型 | Monoclonal |
| 理论分子量 | 88 kDa |
| 浓度 | 1mg/ml |
| 储存液 | 0.01M TBS (pH7.4) with 1% BSA, 0.02% Proclin300 and 50% Glycerol. |
| 研究领域 | Cancer > Signal transduction > Nuclear signaling > STAT family Cardiovascular > Heart > Cardiogenesis > Transcription factors/regulators Cardiovascular > Heart > Hypertrophy > Transcription factors Developmental Biology > Embryogenesis > Embryonic stem cells > Surface molecules Epigenetics and Nuclear Signaling > Nuclear Signaling Pathways > STATs Epigenetics and Nuclear Signaling > Transcription > Other factors Microbiology > Organism > Virus > RNA Virus > ssRNA positive strand virus > SARS Coronavirus Signal Transduction > Signaling Pathway > Nuclear Signaling > STATs Stem Cells > Embryonic Stem Cells > Intracellular |
| 亚基 | Forms a homodimer or a heterodimer with a related family member (at least STAT1). Interacts with IL31RA, NCOA1, PELP1, SIPAR, SOCS7, STATIP1 and TMF1. Interacts with HCV core protein. Interacts with IL23R in presence of IL23. Interacts (via SH2 domain) with NLK. Interacts with ARL2BP; the interaction is enhanced by LIF and JAK1 expression (By similarity). Interacts with KPNA4 and KPNA5; KPNA4 may be the primary mediator of nuclear import (By similarity). Interacts with CAV2; the interaction is increased on insulin-induced tyrosine phosphorylation of CAV2 and leads to STAT3 activation (By similarity). Interacts with ARL2BP; interaction is enhanced with ARL2. Interacts with NEK6 (By similarity). Binds to CDK9 when activated and nuclear. Interacts with BMX. Interacts with ZIPK/DAPK3. Interacts with PIAS3; the interaction occurs on stimulation by IL6, CNTF or OSM and inhibits the DNA binding activity of STAT3. In prostate cancer cells, interacts with STAT3 and promotes DNA binding activity of STAT3. Interacts with STMN3, antagonizing its microtubule-destabilizing activity. |
| 亚细胞定位 | Cytoplasm. Nucleus. Note=Shuttles between the nucleus and the cytoplasm. Translocated into the nucleus upon tyrosine phosphorylation and dimerization, in response to signaling by activated FGFR1, FGFR2, FGFR3 or FGFR4. Constitutive nuclear presence is independent of tyrosine phosphorylation. Predominantly present in the cytoplasm without stimuli. Upon leukemia inhibitory factor (LIF) stimulation, accumulates in the nucleus. The complex composed of BART and ARL2 plays an important role in the nuclear translocation and retention of STAT3. Identified in a complex with LYN and PAG1. |
| 组织特异性 | Heart, brain, placenta, lung, liver, skeletal muscle, kidney and pancreas. |
| 翻译后修饰 | Tyrosine phosphorylated upon stimulation with EGF (By similarity). Tyrosine phosphorylated in response to IL-6, IL-11, CNTF, LIF, CSF-1, EGF, PDGF, IFN-alpha and OSM. Phosphorylated on serine upon DNA damage, probably by ATM or ATR. Serine phosphorylation is important for the formation of stable DNA-binding STAT3 homodimers and maximal transcriptional activity. ARL2BP may participate in keeping the phosphorylated state of STAT3 within the nucleus. |
| 相似性 | Belongs to the transcription factor STAT family. Contains 1 SH2 domain. |
| 功能 | Transcription factor that binds to the interleukin-6 (IL-6)-responsive elements identified in the promoters of various acute-phase protein genes. Activated by IL31 through IL31RA. |
| 保存条件 | Shipped at 4℃. Store at -20℃ for one year. Avoid repeated freeze/thaw cycles. |
| 注意事项 | This product as supplied is intended for research use only, not for use in human, therapeutic or diagnostic applications. |
| 背景资料 | The protein encoded by this gene is a member of the STAT protein family. In response to cytokines and growth factors, STAT family members are phosphorylated by the receptor associated kinases, and then form homo- or heterodimers that translocate to the cell nucleus where they act as transcription activators. This protein is activated through phosphorylation in response to various cytokines and growth factors including IFNs, EGF, IL5, IL6, HGF, LIF and BMP2. This protein mediates the expression of a variety of genes in response to cell stimuli, and thus plays a key role in many cellular processes such as cell growth and apoptosis. The small GTPase Rac1 has been shown to bind and regulate the activity of this protein. PIAS3 protein is a specific inhibitor of this protein. Mutations in this gene are associated with infantile-onset multisystem autoimmune disease and hyper-immunoglobulin E syndrome. Alternative splicing results in multiple transcript variants encoding distinct isoforms. [provided by RefSeq, Sep 2015] |
| 应用 | 推荐稀释比例 |
| {IHC-P} | {1:100-500} |
| {IHC-F} | {1:100-500} |
| {IF} | {1:100-500} |

风险提示:丁香通仅作为第三方平台,为商家信息发布提供平台空间。用户咨询产品时请注意保护个人信息及财产安全,合理判断,谨慎选购商品,商家和用户对交易行为负责。对于医疗器械类产品,请先查证核实企业经营资质和医疗器械产品注册证情况。
 文献和实验
文献和实验[IF={{ 8.109 }}] {Ling Wu. et al. Calcium Channel Blocker Nifedipine Suppresses Colorectal Cancer Progression and Immune Escape by Preventing NFAT2 Nuclear Translocation. Cell Rep. 2020 Oct;33:108327} {IF,IHC} {Human}
[IF={{ 6.3 }}] {Yijia Zhang. et al. β-Catenin mediated TAM phenotype promotes pancreatic cancer metastasis via the OSM/STAT3/LOXL2 axis. NEOPLASIA. 2025 Feb;60:101096} {WB} {Human}
[IF={{ 4.414 }}] {Wei Xiaojin. et al. BMP7 Attenuates Neuroinflammation after Spinal Cord Injury by Suppressing the Microglia Activation and Inducing Microglial Polarization Via the STAT3 Pathway. NEUROCHEM RES. 2023 Apr;:1-14} {IF,WB} {Human}
[IF={{ 3.9 }}] {Zhao JinFeng. et al. Synthesis, biological activities and mechanistic studies of C20-ketone pachysandra alkaloids as anti-hepatocellular carcinoma agents. MOL DIVERS. 2024 Aug;:1-21} {ICC,WB} {Human}
 技术资料
技术资料暂无技术资料 索取技术资料





